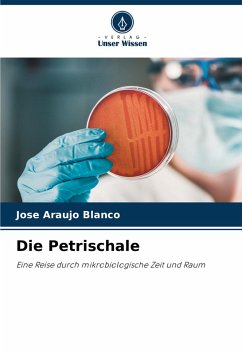

Karl August Möbius
Broschiertes Buch
Foraminifera von Mauritius
Versandkostenfrei!
Versandfertig in 1-2 Wochen
Weitere Ausgaben:

PAYBACK Punkte
0 °P sammeln!


Produktdetails
- Verlag: Springer / Springer Netherlands / Springer, Berlin
- Artikelnr. des Verlages: 978-94-017-6465-0
- Softcover reprint of the original 1st ed. 1970
- Seitenzahl: 80
- Erscheinungstermin: 1. Januar 1970
- Deutsch
- Abmessung: 297mm x 210mm x 5mm
- Gewicht: 238g
- ISBN-13: 9789401764650
- ISBN-10: 9401764654
- Artikelnr.: 40769624
Herstellerkennzeichnung
Springer-Verlag GmbH
Tiergartenstr. 17
69121 Heidelberg
ProductSafety@springernature.com
Für dieses Produkt wurde noch keine Bewertung abgegeben. Wir würden uns sehr freuen, wenn du die erste Bewertung schreibst!
Eine Bewertung schreiben
Eine Bewertung schreiben
Andere Kunden interessierten sich für